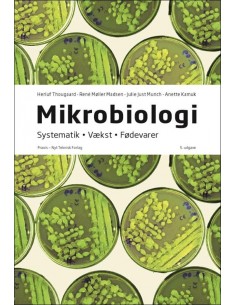
Mikrobiologi

Your cart
Es gibt keine Artikel mehr in Ihrem Warenkorb
Organisation, udvikling og samskabelse
OBS! Ny udgave august 2025, benyt SBN 9788759342985
Ligesom organisationer og forventningerne til god ledelse forandrer sig, så har denne bog også forandret sig. Derfor er bogens titel tilpasset det opdaterede indhold. Ledelse, organisering og strategisering: Organisation, udvikling og samskabelse sætter fokus på den kompleksitet og den mangfoldighed af perspektiver og tilgange til organisationsfeltet, som ledere møder.Bogen adskiller sig fra de fleste eksisterende organisationsteoretiske lærebøger ved at indtænke organisationen og dennes udvikling i en ledelsesmæssig kontekst. Forfatterne belyser organisationen i forhold til de rammer, der gives for ledelse i dag, og de udviklingsmønstre, der tegner sig for ledelse fremover. Bogen giver en grundig indføring i centrale temaer og behandler såvel klassiske som nye teorier. I denne 3. udgave er kapitlerne revideret, tre kapitler er taget ud og tre nye kapitler om adaptiv ledelse, økonomi- og ressourcestyring samt strategisk styringsarkitektur er kommet til.Ledelse, organisering og strategisering: Organisation, udvikling og samskabelse henvender sig først og fremmest til studerende på lederuddannelser på diplom- og bachelorniveau og på andre videregående uddannelser, hvor der undervises i organisationsteori i en ledelsesmæssig kontekst. Men bogen kan også med fordel læses af andre med interesse for ledelse og organisation.Bogens forfattere har alle en baggrund i organisationsforskning, ledelse og ledelses- og strategirådgivning og repræsenterer tilsammen mange års forskning og praktisk erfaring med ledelse, organisation og strategi. Med bogen giver de et spændende indblik i feltet for både den studerende og den erfarne leder.
Ligesom organisationer og forventningerne til god ledelse forandrer sig, så har denne bog også forandret sig. Derfor er bogens titel tilpasset det opdaterede indhold. Ledelse, organisering og strategisering: Organisation, udvikling og samskabelse sætter fokus på den kompleksitet og den mangfoldighed af perspektiver og tilgange til organisationsfeltet, som ledere møder.Bogen adskiller sig fra de fleste eksisterende organisationsteoretiske lærebøger ved at indtænke organisationen og dennes udvikling i en ledelsesmæssig kontekst. Forfatterne belyser organisationen i forhold til de rammer, der gives for ledelse i dag, og de udviklingsmønstre, der tegner sig for ledelse fremover. Bogen giver en grundig indføring i centrale temaer og behandler såvel klassiske som nye teorier. I denne 3. udgave er kapitlerne revideret, tre kapitler er taget ud og tre nye kapitler om adaptiv ledelse, økonomi- og ressourcestyring samt strategisk styringsarkitektur er kommet til.Ledelse, organisering og strategisering: Organisation, udvikling og samskabelse henvender sig først og fremmest til studerende på lederuddannelser på diplom- og bachelorniveau og på andre videregående uddannelser, hvor der undervises i organisationsteori i en ledelsesmæssig kontekst. Men bogen kan også med fordel læses af andre med interesse for ledelse og organisation.Bogens forfattere har alle en baggrund i organisationsforskning, ledelse og ledelses- og strategirådgivning og repræsenterer tilsammen mange års forskning og praktisk erfaring med ledelse, organisation og strategi. Med bogen giver de et spændende indblik i feltet for både den studerende og den erfarne leder.
- Autor
- Mette Elting og Sverri Hammer (red.)
- ISBN13
- 9788759334003
- ISBN10
- 8759334002
- Auflage / Jahr
- 3 / 2019
- Verlag
- Samfundslitteratur
- Seitenzahl
- 431
- Bindung
- Paperback